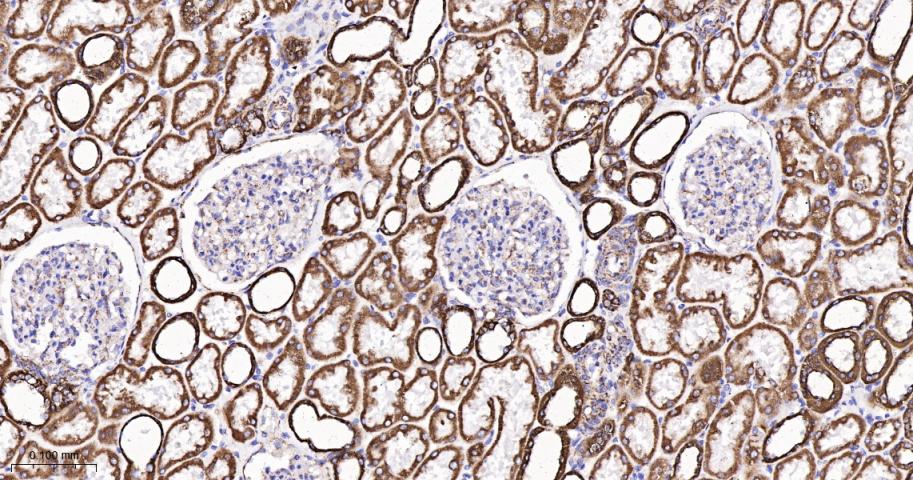
细胞色素c氧化酶亚型2重组兔单抗-bsm-52542R

MTCO2 Recombinant Rabbit mAb (一抗) - WB,IHC-P,IHC-F,IF,Flow-Cyt | Bioss
Rrmab?兔单抗

货号:bsm-52542R
产品详情
相关标记
相关产品
相关文献
常见问题
概述
产品编号
bsm-52542R
产品类型
重组兔单抗、mIHC精品抗体
英文名称
MTCO2 Recombinant Rabbit mAb
中文名称
细胞色素c氧化酶亚型2重组兔单抗
英文别名
COII; MTCO2; COX2_HUMAN; MT-CO2; Cytochrome c oxidase polypeptide II; 7.1.1.9; COX2; COXII;
抗体来源
Rabbit
免疫原
KLH conjugated synthetic peptide derived from human MTCO2: 180-227/227
亚型
IgG
性状
Liquid
纯化方法
affinity purified by Protein A
克隆类型
Recombinant
克隆号
6C9
理论分子量
25 kDa
检测分子量
20 kDa
浓度
1mg/ml
储存液
0.01M TBS (pH7.4) with 1% BSA, 0.02% Proclin300 and 50% Glycerol.
研究领域
Cancer > Cancer Metabolism > Metabolic signaling pathway > Integration of energy metabolism
Metabolism > Pathways and Processes > Metabolic signaling pathways > Energy transfer pathways > Integration of energy
Metabolism > Pathways and Processes > Mitochondrial Metabolism > Cytochromes
Metabolism > Pathways and Processes > Mitochondrial Metabolism > Mitochondrial markers
Metabolism > Pathways and Processes > Mitochondrial Metabolism > Oxidative phosphorylation > Complex IV
SWISS
Gene ID
保存条件
Shipped at 4℃. Store at -20℃ for one year. Avoid repeated freeze/thaw cycles.
注意事项
This product as supplied is intended for research use only, not for use in human, therapeutic or diagnostic applications.
产品介绍
细胞色素c氧化酶的组成部分,是线粒体电子传递链中最后一个推动氧化磷酸化的酶。呼吸链包含3个多亚单位复合物琥珀酸脱氢酶(复合体II,CII)、泛醌细胞色素c氧化还原酶(细胞色素b-c1复合物,复合体III,CIII)和细胞色素c氧化酶(复合体IV,CIV),它们协同将NADH和琥珀酸衍生的电子转移到分子氧中,在内膜上形成一个电化学梯度来驱动跨膜转运和ATP合成酶。细胞色素c氧化酶是也是呼吸链的组成部分,催化氧气还原为水。在膜间空间(IMS)中,来自还原细胞色素c的电子通过亚基2的双核铜A中心(CU(A))和亚单位1的血红素A转移到亚单位1中的活性位点,亚基1是由血红素A3和铜B(CU(B))形成的双核中心(BNC)。BNC利用IMS中细胞色素c的4个电子和线粒体基质中的4个质子将分子氧还原为2个水分子。
背景资料
Contributes to cytochrome-c oxidase activity. Predicted to be involved in mitochondrial electron transport, cytochrome c to oxygen and positive regulation of vasoconstriction. Located in mitochondrial inner membrane. Part of respiratory chain complex IV. Biomarker of Huntington's disease and stomach cancer. [provided by Alliance of Genome Resources, Apr 2022]

产品应用
| 应用 | 已检合格种属 | 预测种属 | 推荐稀释比例 |
|---|---|---|---|
| WB | Human | 1:500-2000 | |
| IHC-P | Human | 1:100-500 | |
| IHC-F | Human | 1:100-500 | |
| IF | Human | 1:100-500 | |
| Flow-Cyt | Human | 1:50-100 |
交叉反应
交叉反应: Human
相关产品
暂无相关产品
靶标
基因名
MT-CO2
蛋白名
Cytochrome c oxidase subunit 2
亚细胞定位
Mitochondrion inner membrane; Multi-pass membrane protein.
翻译后修饰
Defects in MT-CO2 are a cause of mitochondrial complex IV deficiency (MT-C4D) [MIM:220110]; also known as cytochrome c oxidase deficiency. A disorder of the mitochondrial respiratory chain with heterogeneous clinical manifestations, ranging from isolated myopathy to severe multisystem disease affecting several tissues and organs. Features include hypertrophic cardiomyopathy, hepatomegaly and liver dysfunction, hypotonia, muscle weakness, excercise intolerance, developmental delay, delayed motor development and mental retardation. A subset of patients manifest Leigh syndrome.
疾病
Defects in MT-CO2 are a cause of mitochondrial complex IV deficiency (MT-C4D) [MIM:220110]; also known as cytochrome c oxidase deficiency. A disorder of the mitochondrial respiratory chain with heterogeneous clinical manifestations, ranging from isolated myopathy to severe multisystem disease affecting several tissues and organs. Features include hypertrophic cardiomyopathy, hepatomegaly and liver dysfunction, hypotonia, muscle weakness, excercise intolerance, developmental delay, delayed motor development and mental retardation. A subset of patients manifest Leigh syndrome.
相似性
Belongs to the cytochrome c oxidase subunit 2 family.
功能
Cytochrome c oxidase is the component of the respiratory chain that catalyzes the reduction of oxygen to water. Subunits 1-3 form the functional core of the enzyme complex. Subunit 2 transfers the electrons from cytochrome c via its binuclear copper A center to the bimetallic center of the catalytic subunit 1.
同靶标产品
相关文献
提示: 发表研究结果有使用 bsm-52542R 时请让我们知道,以便我们可以引用参考文章。作为回馈,资料提供者将获得我们送上的小礼品。